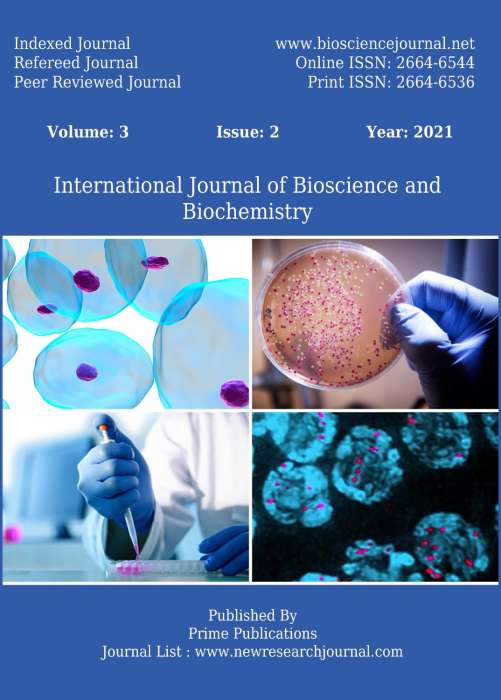

Offer details
Free Shipping option:
International Journal of Molecular Biology and Biochemistry has free shipping option available. When you choose this option, all subscribed issues are delivered free to your door step.
Shipping by Courier / Registered post option:
Now get all issues of your subscription by courier / registered post when you choose this option. Say goodbye to missed issues. Please note mode of shipment will be either by courier or registered post, as available with the publisher.
DDiscounts:
Get upto a maximum of 10% discount when you order for International Journal of Molecular Biology and Biochemistry. No coupon codes are required, simply choose and place your order to avail the discount offer.
About International Journal of Molecular Biology and Biochemistry
International Journal of Molecular Biology and Biochemistry is a peer reviewed, indexed, refereed and open access journal. Considers review and research articles related to molecular biology and biochemistry, Biotechnology, Genomics and Bioinformatics, Molecular Biology, Stem Cell Biology, Stem Cells & Development, Cancer stem cells, Biochemical Engineering, Bioprocess Engineering, Multipotent stem cell, Nucleus, Medical Biotechnology, Agro, Food Biotechnology, Bone Transplantation, Cells Tissues Organs, Cell Transplantation, Cytotherapy, Biomedicine, Plant biology, Phytochemistry, Cancer Stem Cells Tumor, Experimental Hematology, Transplantation lymphoma, Stem cell genomes, Embryonic stem cell, Agricultural and Medicinal plants, Crop Productivity, Reproductive Biology and Toxicology, Biochemical Toxicology, DNA Damage and Repair, Plant molecular biotechnology Fetus, Gamete, Gene, Induced pluripotent stem cell, Passage, Totipotent stem cell, etc.
How to subscribe International Journal of Molecular Biology and Biochemistry
To subscribe to International Journal of Molecular Biology and Biochemistry please choose the subscription option from the offer(s) given above by clicking on "Add to cart" or "Buy now". After you click, you will be asked to confirm if this is a renewal order. Incase it is renewal, we recommend you give correct current subscription number. If you do not remember the subscription number you may leave it blank, however this may delay the activation of your subscription.
Publisher Profile - AkiNik Publications
AkiNik Publications is a leading provider of high-quality publishing and knowledge dissemination solutions. We currently print a number of scholarly research journals in a variety of disciplines.
 100% Assured
100% Assured

Reviews
There are no reviews yet.